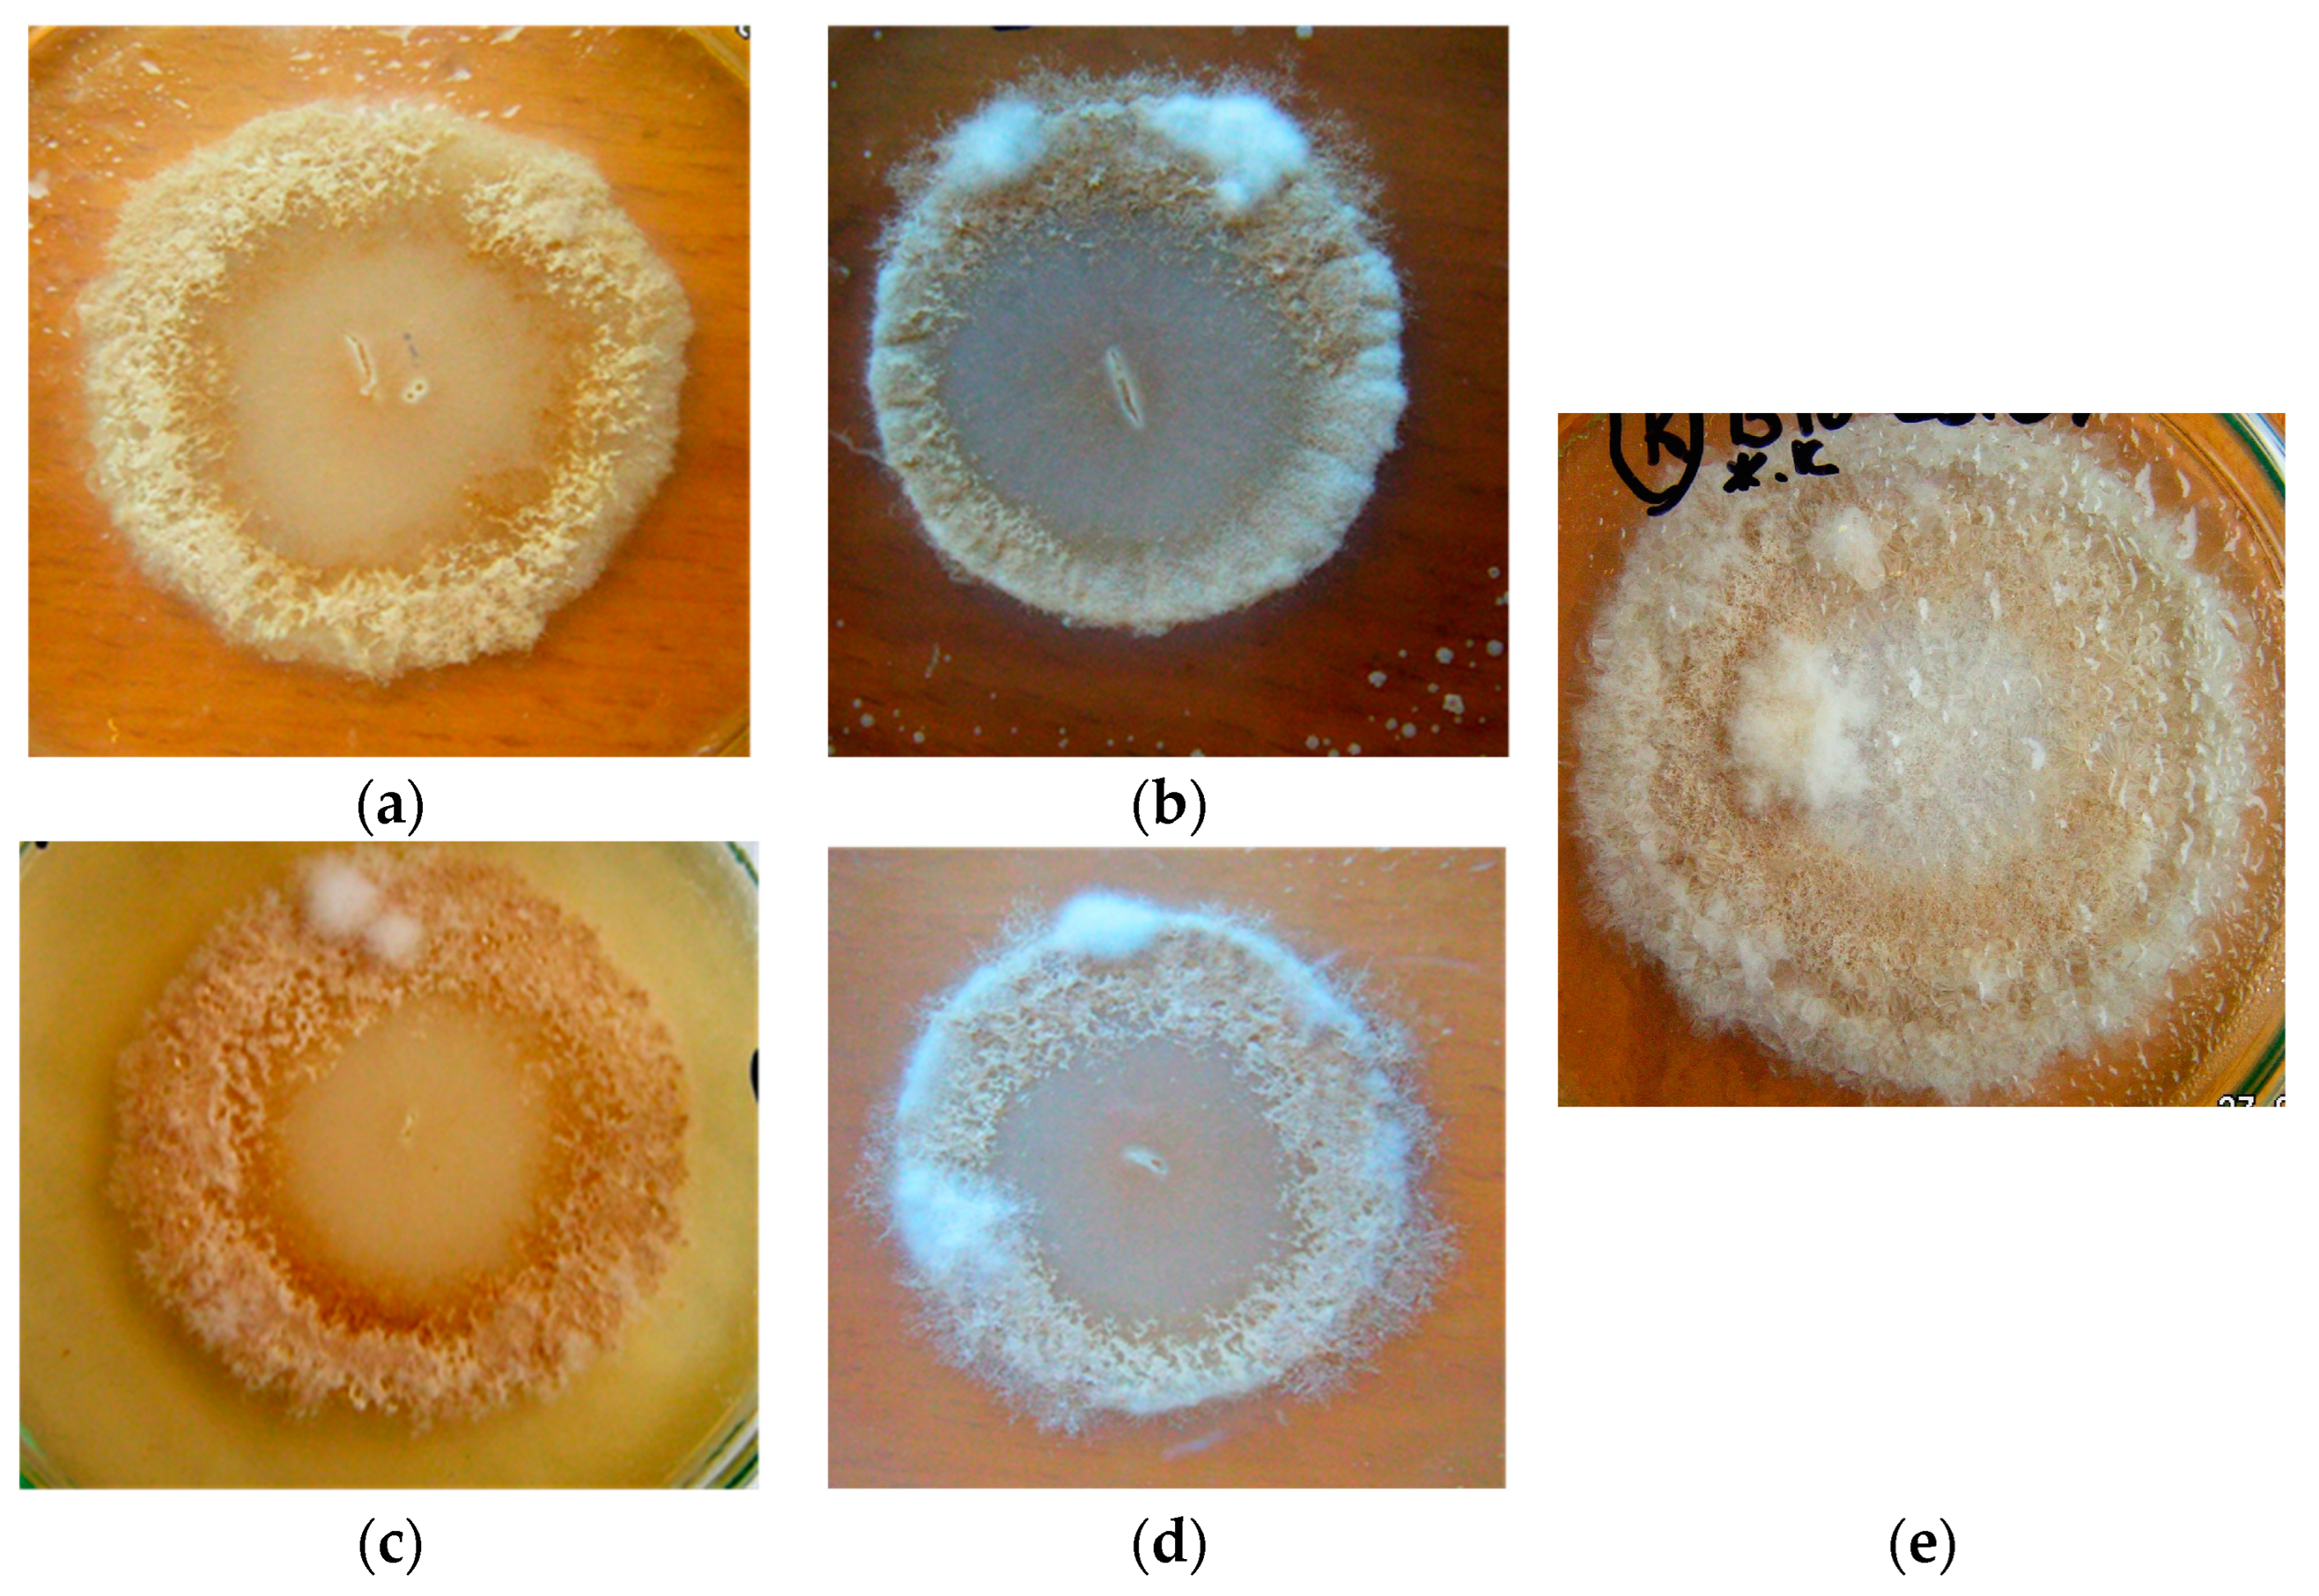
Microorganisms 11 02056 g003 Microorganisms 11 02056 g003

Antifungal Activity of Industrial Bacillus Strains against Mycogone perniciosa, the Causative Agent of Wet Bubble Disease in White Button Mushrooms
Abstract
1. Introduction
2. Materials and Methods
2.1. Materials Used in the Research
2.2. Research Objects
2.3. Research Methods
2.4. Statistical Processing Methods
3. Results
3.1. Antifungal Activity of B. subtilis Strains against 1-Day-Old M. perniciosa Mycelium
3.2. Antifungal Activity of B. subtilis Strains against 7-Day-Old M. perniciosa Mycelium
3.3. Antifungal Activity of B. subtilis Strains Secondary Metabolites against M. perniciosa
4. Discussion
5. Conclusions
Author Contributions
Funding
Data Availability Statement
Acknowledgments
Conflicts of Interest
References
- Sarka, A.; Archana, T.S. Production of Button Mushroom (Agaricus bisporus), Pharmacological Applications and Pest Management. In Recent Advances in Mushroom Cultivation Technology and Its Application; Kulshreshtha, S., Prince Onyedinma, U., Siddhant, Eds.; Bright Sky Publications: New Delhi, India, 2022; Volume 2, pp. 111–134. [Google Scholar] [CrossRef]
- Lu, H.; Lou, H.; Hu, J.; Liu, Z.; Chen, Q. Macrofungi: A review of cultivation strategies, bioactivity, and application of mushrooms. Compr. Rev. Food Sci. Food Saf. 2020, 19, 2333–2356. [Google Scholar] [CrossRef]
- Rhaman, S.M.S.A.; Naher, L.; Siddiquee, S. Mushroom Quality Related with Various Substrates’ Bioaccumulation and Translocationof Heavy Metals. J. Fungi 2022, 8, 42. [Google Scholar] [CrossRef] [PubMed]
- Amin, Z.; Wani, F.F.; Gulzar, H.; Dar, W.A.; Sheikh, P.A. Diseases of White Button Mushroom (Agaricus bisporus)–A Potential Threat to Mushroom Industry. Int. J. Curr. Microbiol. App. Sci. 2021, 10, 2076–2085. [Google Scholar] [CrossRef]
- Aminuzzaman, F.M.; Shahi, S.; Thapa, S.; Das, K. Mushroom Diseases and Their Management: A Review. In Recent Advances in Mushroom Cultivation Technology and Its Application; Kulshreshtha, S., Prince Onyedinma, U., Siddhant, Eds.; Bright Sky Publications: New Delhi, India, 2022; Volume 2, pp. 1–27. [Google Scholar] [CrossRef]
- Munshi, N.A.; Dar, G.H.; Ghani, M.Y.; Kauser, S.; Mughal, N. Button Mushroom Cultivation; Communication and Publication Centre SKUAST-K.1: New Delhi, India, 2010; pp. 1–33. [Google Scholar]
- Gupta, S.; Summuna, B.; Singh, R.; Gupta, M.; Gupta, A. Mushroom Diseases: A potential threat to mushroom cultivation. In Transformation of Indian Agriculture through Innovative Technologies; Astral International Pvt. Ltd.: Delhi, India, 2018; Volume 5, pp. 57–70. [Google Scholar]
- Archana, T.S.; Vaja, S. A Review on Diseases of Button Mushroom (Agaricus spp.): A Potential Hazard to Mushroom Cultivation. In Recent Advances in Mushroom Cultivation Technology and Its Application; Kulshreshtha, S., Prince Onyedinma, U., Siddhant, Eds.; Bright Sky Publications: New Delhi, India, 2022; Volume 2, pp. 135–149. [Google Scholar] [CrossRef]
- Deng, Y.; Wu, X.; Wen, D.; Huang, H.; Chen, Y.; Mukhtar, I.; Yue, L.; Wang, L.; Wen, Z. Intraspecific mitochondrial DNA comparison of mycopathogen Mycogone perniciosa provides insight into mitochondrial transfer RNA introns. Phytopathology 2021, 111, 639–648. [Google Scholar] [CrossRef] [PubMed]
- Du, Y.; Shi, N.; Ruan, H.; Chen, F. Three Mycogone species, including a new species, cause wet bubble disease of Agaricus bisporus in China. Plant Dis. 2021, 105, 3967–3977. [Google Scholar] [CrossRef]
- Sharma, S.R.; Kumar, S.; Sharma, V.P. Diseases and Competitor Moulds of Mushrooms and their Management; National Research Centre for Mushroom: Solan, India; New Delhi, India, 2007; pp. 1–86. [Google Scholar]
- Shi, N.; Ruan, H.; Jie, Y.; Chen, F.; Du, Y. Sensitivity and efficacy of fungicides against wet bubble disease of Agaricus bisporus caused by Mycogone perniciosa. Eur. J. Plant Pathol. 2020, 157, 873–885. [Google Scholar] [CrossRef]
- Altaf, S.; Jan, S.K.; Ahanger, S.A.; Basu, U.; Rather, R.A.; Wani, O.A.; Rasool, F.; Mushtaq, M.; Yassin, M.T.; Mostafa, A.A.-F.; et al. Management of Green Mold Disease in White Button Mushroom (Agaricus bisporus) and Its Yield Improvement. J. Fungi 2022, 8, 554. [Google Scholar] [CrossRef]
- Titova, J.A. Mycobiota associated with the various stages of Agaricus bisporus morphogenesis. Mycol. Phytopathol. 2000, 34, 32–39. (In Russian) [Google Scholar]
- Titova, J.A. Mycosinusia on the different Agaricus bisporus sorts. Mycol. Phytopathol. 2000, 34, 25–32. (In Russian) [Google Scholar]
- Titova, J.A. The influence of temperature on the interactions between cultivated mushroom Agaricus bisporus (Lange) Imbach and its pathogens. In Proceedings of the International Conference “Mycology and Cryptogamic Botany in Russia: Traditions and Modern State”, Devoted to 100th Anniversary of Investigations on Mycology and Cryptogamic Botany in V.L. Komarov Botanical Institute RAS, St. Petersburg, Russia, 24–28 April 2000; pp. 260–262. (In Russian). [Google Scholar]
- Titova, J.A. Biological Bases for the White Button Mushroom Fungal Diseases Control. Ph.D. Thesis, All-Union Research Institute of Plant Protection, St. Petersburg, Russia, 2000. (In Russian). Available online: https://www.dissercat.com/content/biologicheskie-osnovy-borby-s-gribnymi-boleznyami-shampinonov (accessed on 31 May 2023).
- Kouser, S.; Shah, S.; Ahmed, M.; Shah, M.D.; Sheikh, P.A. Morphological characteristics of wet bubble disease (Mycogone perniciosa) isolated from button mushroom (Agaricus bisporus) and assessment of factors affecting disease development and spread. Afr. J. Microbiol. Res. 2015, 9, 185–193. [Google Scholar] [CrossRef]
- Miller, F.C.; Spair, M. Very large-scale commercial trial of a biological control for mushroom blotch disease. In Science and Cultivation of Edible Fungi; Elliott, T.J., Balkema, A.A., Eds.; CRC Press: Rotterdam, NL, USA, 1995; pp. 635–642. [Google Scholar]
- Altaf, S.; Jan, S.K.; Basu, U.; Ahanger, S.A.; Dave, A.; Kakraliya, S.S.; Baazeem, A.; Mishra, A.K.; Kumar, A.; Shah, I.A.; et al. Sustainable Management of Green Mold Disease of White Button Mushroom Using Botanicals and Biocontrol Agents under Temperate Conditions. Horticulturae 2022, 8, 768. [Google Scholar] [CrossRef]
- Pavlyusin, V.A.; Novikova, I.I.; Boikova, I.V. Microbiological control in phytosanitary optimization technologies for agroecosystems: Research and practice (review). Agric. Biol. 2020, 55, 421–438. [Google Scholar] [CrossRef]
- State Catalog of Pesticides and Agrochemicals Permitted for Use in Russian Federation Territory; Minselkhoz: Moscow, Russia, 2023; Volume 3, pp. 905–939. (In Russian)
- Titova, J.A.; Lobanova, N.V.; Novikova, I.I. Wet bubble disease microbiocontrol of white button mushroom Agaricus bisporus (Lange) Imbach. In Proceedings of the Scientific-practical Conference “Mushroom growing and tied biotechnologies. Innovations to invest”, Moscow, Russia, 7–11 October 2005; pp. 10–11. (In Russian). [Google Scholar]
- Titova, J.A. Spent Mushroom Substrates Valorization via Brand New Multirecycled Polyfunctional Biologics Producing on Them. Waste Biomass Valor 2021, 13, 1089–1100. [Google Scholar] [CrossRef]
- Titova, J.A. Multirecycled biotechnology for liquid-phase polyfunctional biopesticides obtaining. In Proceedings of the 5th International Mycological Forum “Modern Mycology in Russia; National Academy of Mycology: Moscow, Russia, 2022; Volume 9, pp. 410–412. (In Russian). [Google Scholar]
- Experimental Mycology Methods: A Handbook; Nauk Dumka: Kiev, Ukraine, 1982. (In Russian)
- Peacock, J.L.; Peacock, P.J. Oxford Handbook of Medical Statistics; GB; Oxford University Press: Cary, NC, USA, 2011. [Google Scholar] [CrossRef]
- Petrie, A.; Sabin, C. Medical Statistics at a Glance; Wiley Blackwell: Hoboken, NJ, USA, 2019. [Google Scholar]
- Wang, X.; Liang, L.; Shao, H.; Ye, X.; Yang, X.; Chen, X.; Shi, Y.; Zhang, L.; Xu, L.; Wang, J. Isolation of the Novel Strain Bacillus amyloliquefaciens F9 and Identification of Lipopeptide Extract Components Responsible for Activity against Xanthomonas citri subsp. Citri. Plants 2022, 7, 457. [Google Scholar] [CrossRef] [PubMed]
- Saravanan, R.; Nakkeeran, S.; Saranya, N.; Senthilraja, C.; Renukadevi, P.; Krishnamoorthy, A.S.; Enshasy, H.A.E.; El-Adawi, H.; Malathi, V.G.; Salmen, S.H.; et al. Mining the Genome of Bacillus velezensis VB7 (CP047587) for MAMP Genes and Non-Ribosomal Peptide Synthetase Gene Clusters Conferring Antiviral and Antifungal Activity. Microorganisms 2021, 9, 2511. [Google Scholar] [CrossRef]
- Lai, K.; Chen, S.; Hu, M.; Hu, Q.; Geng, P.; Weng, Q.; Jia, J. Control of postharvest green mold of citrus fruit by application of endophytic Paenibacillus polymyxa strain SG-6. Postharvest Biol. Technol. 2012, 69, 40–48. [Google Scholar] [CrossRef]
- Hong, P.; Hao, W.; Luo, J.; Chen, S.; Hu, M.; Zhong, G. Combination of hot water, Bacillus amyloliquefaciens HF-01 and sodium bicarbonate treatments to control postharvest decay of mandarin fruit. Postharvest Biol. Technol. 2014, 88, 96–102. [Google Scholar] [CrossRef]
- Zhang, J.; Huang, X.; Hou, Y.; Xia, X.; Zhu, Z.; Huang, A.; Feng, S.; Li, P.; Shi, L.; Dong, P. Isolation and Screening of Antagonistic Endophytes against Phytophthora infestans and Exploration on Anti-oomycete Mechanism of Bacillus velezensis 6-5. Plants 2023, 12, 909. [Google Scholar] [CrossRef]
- Hong, S.; Kim, T.Y.; Won, S.J.; Moon, J.H.; Ajuna, H.B.; Kim, K.Y.; Ahn, Y.S. Control of Fungal Diseases and Fruit Yield Improvement of Strawberry Using Bacillus velezensis CE 100. Microorganisms 2022, 10, 365. [Google Scholar] [CrossRef]
- Zhang, P.; Xie, G.; Wang, L.; Xing, Y. Bacillus velezensis BY6 Promotes Growth of Poplar and Improves Resistance Contributing to the Biocontrol of Armillaria solidipes. Microorganisms 2022, 10, 2472. [Google Scholar] [CrossRef]
- Ahmed, H.F.A.; Seleiman, M.F.; Al-Saif, A.M.; Alshiekheid, M.A.; Battaglia, M.L.; Taha, R.S. Biological Control of Celery Powdery Mildew Disease Caused by Erysiphe heracleid DC In Vitro and In Vivo Conditions. Plants 2021, 10, 2342. [Google Scholar] [CrossRef] [PubMed]
- Ivanova, T.V.; Boyko, O.A.; Melnychuk, M.D. Monitoring of mushrooms Agaricus bisporus (J. Lge) Imbach: Diagnostics and prevention of diseases. Live Bio-Abiotic Syst. 2014, 8. (In Russian) [Google Scholar] [CrossRef]
- Stanojević, O.; Berić, T.; Potočnik, I.; Rekanović, E.; Stanković, S.; Milijašević-Marčić, S. Biological control of green mould and dry bubble diseases of cultivated mushroom (Agaricus bisporus L.) by Bacillus spp. Crop Prot. 2019, 126, 104944. [Google Scholar] [CrossRef]
- Pandin, C.; Coq, D.L.; Deschamps, J.; Védie, R.; Rousseau, T.; Aymerich, S.; Briandet, R. Complete genome sequence of Bacillus velezensis QST713: A biocontrol agent that protects Agaricus bisporus crops against the green mould disease. J. Biotechnol. 2018, 278, 10–19. [Google Scholar] [CrossRef]
- Pandin, C.; Védie, R.; Rousseau, T.; Le Coq, D.; Aymerich, S.; Briandet, R. Dynamics of compost microbiota during the cultivation of Agaricus bisporus in the presence of Bacillus velezensis QST713 as biocontrol agent against Trichoderma aggressivum. Biol. Contr. 2018, 127, 39–54. [Google Scholar] [CrossRef]
- Fletcher, J.T.; Drakes, G.D.; Talent, C.J.W. The control of wet bubble disease of mushrooms caused by Mycogone perniciosa. Ann. Appl. Biol. 2008, 79, 35–41. [Google Scholar] [CrossRef]
- Szumigaj-Tarnowska, J.; Uliński, Z.; Ślusarski, C. Efficacy assessment of selected fungicides in the control of wet bubble (Mycogone perniciosa) in white button mushroom (Agaricus bisporus). Prog. Plant Prot. 2015, 55, 107–113. [Google Scholar] [CrossRef]
- Sharma, V.P.; Kumar, S.; Kamal, S. Management of wet bubble disease (Mycogone perniciosa) in Agaricus bisporus. Mushroom Res. 2018, 26, 181–191. [Google Scholar]
- Novikova, I.I.; Boikova, I.V.; Pavlyushin, V.A.; Zeyruk, V.N.; Vasilieva, S.V.; Azizbekyan, R.R.; Kuznetsova, N.I. Application perspectives for biopreparations based on microbe-antagonists for potato disease control at storage. Plant Prot. News 2013, 4, 12–21. (In Russian) [Google Scholar]
- Shenin Yu, D.; Novikova, I.I.; Kruglikova, L.F.; Kal’ko, G.V. Alirin B characteritics as the main fungicide component produced by strain Bacillus subtilis-10-VIZR. Antibiot. Chemother. 1995, 40, 3–7. (In Russian) [Google Scholar]
- Novikova, I.I.; Shenin, Y.D. Separation, identification and antifungal activity of gamair complex metabolites produced by strain Bacillus subtilis M-22–The biologic producer for plant protection against mycoses and bacterioses. Biotechnology 2011, 47, 45–58. (In Russian) [Google Scholar]
- Titova, J.A. New biologics for plant protection based on extracts of multiconverted substrates. In Advances in Medical Mycology; National Academy of Mycology: Moscow, Russia, 2023; Volume 25, pp. 444–448. (In Russian) [Google Scholar]

Disclaimer/Publisher’s Note: The statements, opinions and data contained in all publications are solely those of the individual author(s) and contributor(s) and not of MDPI and/or the editor(s). MDPI and/or the editor(s) disclaim responsibility for any injury to people or property resulting from any ideas, methods, instructions or products referred to in the content. |
© 2023 by the authors. Licensee MDPI, Basel, Switzerland. This article is an open access article distributed under the terms and conditions of the Creative Commons Attribution (CC BY) license (https://creativecommons.org/licenses/by/4.0/).
Share and Cite
Novikova, I.; Titova, J. Antifungal Activity of Industrial Bacillus Strains against Mycogone perniciosa, the Causative Agent of Wet Bubble Disease in White Button Mushrooms. Microorganisms 2023, 11, 2056. https://doi.org/10.3390/microorganisms11082056
Novikova I, Titova J. Antifungal Activity of Industrial Bacillus Strains against Mycogone perniciosa, the Causative Agent of Wet Bubble Disease in White Button Mushrooms. Microorganisms. 2023; 11(8):2056. https://doi.org/10.3390/microorganisms11082056
Chicago/Turabian StyleNovikova, Irina, and Julia Titova. 2023. "Antifungal Activity of Industrial Bacillus Strains against Mycogone perniciosa, the Causative Agent of Wet Bubble Disease in White Button Mushrooms" Microorganisms 11, no. 8: 2056. https://doi.org/10.3390/microorganisms11082056
APA StyleNovikova, I., & Titova, J. (2023). Antifungal Activity of Industrial Bacillus Strains against Mycogone perniciosa, the Causative Agent of Wet Bubble Disease in White Button Mushrooms. Microorganisms, 11(8), 2056. https://doi.org/10.3390/microorganisms11082056

